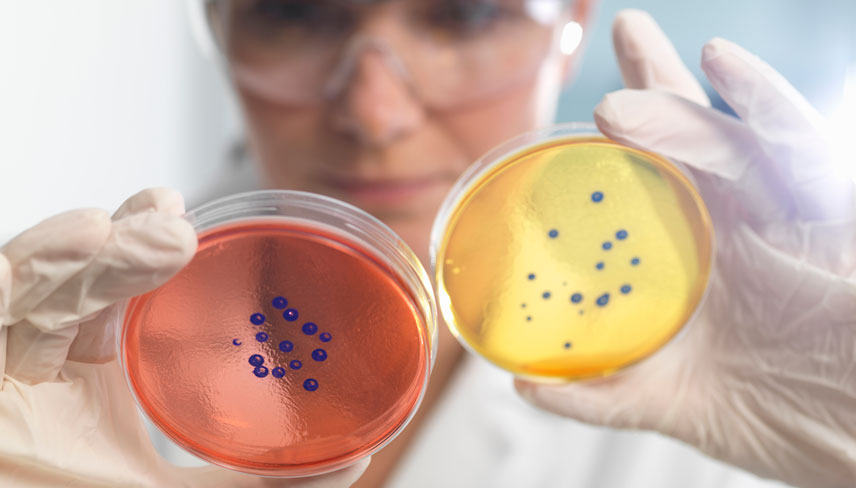
woman comparing two petri dishes

Qualified Presumption of Safety (QPS)
17 Jun 2024
What it Means for your Food Ingredient in the European Union
The Qualified Presumption of Safety (QPS) approach was designed to allow a more simplified, harmonized, and efficient safety assessment of microorganisms intended for use in the food and feed supply in the European Union (EU). This approach was first implemented in 2007 and is based on an assessment of published data on the taxonomic identity, the body of relevant knowledge, and safety concerns for the taxonomic unit (TU) of a microorganism.[1]
A QPS assessment cannot be initiated directly by an applicant. Rather, when a regulated product application is submitted for authorisation, the European Food and Safety Authority (EFSA) will share the application with the Biological Hazards (BIOHAZ) Team for a future assessment. The full updated list of microorganisms that have been notified to EFSA is available on their website,[2] and includes the microbiological group/subgroup, genus, species, strain, regulated product category, intended use, application number, and evaluation year. The current QPS list is available [3] and is a positive list of all notified TUs that have QPS status. Microorganisms listed as QPS include (but are not limited to) Lactobacillus acidophilus, Bifidobacterium bifidum, Euglena gracilis, and Saccharomyces cerevisiae. In some instances, QPS status comes with a qualification such as “for production purposes only” (i.e., there is an absence of the viable production organism in the final product), “absence of genetic determinants for toxigenic activity,” and “strains should not harbour any acquired antimicrobial resistance genes to clinically relevant antimicrobials,” to name a few.
Reasons for microorganisms being excluded from a BIOHAZ evaluation include ambiguous taxonomic identity or strain-specific harmful traits. In the 2024 update, it was also clarified that QPS status can extend to genetically modified microorganisms (GMMs), as long as the GMM is derived from a QPS parental strain, and that the genetic modifications do not give rise to safety concerns. This update is an important clarification for the food industry.
A key consideration, which is often overlooked, is the fact that the presence of a microorganism on the QPS list does not automatically mean one can go to market with an ingredient derived therefrom. Instead, the presence of a microorganism on the QPS list means a pre-assessment of safety has been conducted, which reduces the need for assessments of antimicrobial activity, toxigenicity, and pathogenicity, and potentially reduces the need for toxicological studies to demonstrate the safety of the final ingredient. In other words, the safety assessment may not be as exhaustive.[4]
In a recent example, in its evaluation of docosahexaenoic acid (DHA) oil from Schizochytrium limacinum (strain TKD-1) as a novel food for use in infant and follow-on formula, EFSA considered the safety of the ingredient could be concluded as safe without the need to generate toxicology studies – considering (amongst other elements) the QPS status of the source organism. [5]
In contrast, safety could not be conferred for DHA oil from Schizochytrium sp. (strain ATCC 20889) for use in infant and follow-on formula as a novel food. In this case, the applicant could not demonstrate that the strain belonged to a species of Schizochytrium that has QPS status, and thus EFSA could not use the toxicological studies conducted with other DHA-rich algal oils derived from Schizochytrium sp. to support the safety of the novel food ingredient. Ultimately, the safety of the novel food could not be established.[6]
In conclusion, having an organism on the QPS list helps alleviate the burden of data required to demonstrate safety within the EU, and should be strongly considered when choosing a species for ingredient production, however, it does not negate other risk assessment considerations (composition, production process details, absence of marine biotixins etc), nor the requirement for pre-market approval.
Intertek has extensive experience with overcoming regulatory hurdles and developing unique strategic pathways. If you have any questions, feel free to contact us at food.sci-reg@intertek.com.
Disclaimer: The foregoing does not constitute legal or regulatory advice and the reader should seek professional guidance for their specific requirements and conditions. Please contact our expert compliance team for further assistance in this regard.
To learn more about how we can support your business, visit: https://www.intertek.com/assuris/food/
- https://www.efsa.europa.eu/en/applications/qps-assessment
- https://zenodo.org/records/10477679
- Up to date at time of publication
- https://efsa.onlinelibrary.wiley.com/doi/epdf/10.2903/j.efsa.2021.6555
- https://efsa.onlinelibrary.wiley.com/doi/epdf/10.2903/j.efsa.2023.8414
- https://efsa.onlinelibrary.wiley.com/doi/epdf/10.2903/j.efsa.2022.7083
